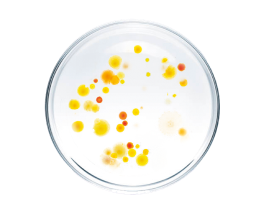
bakterie

- BACTEROMIC
Our Solution
MEET BACTEROMIC - A UNIQUE DIAGNOSTIC SOLUTION
The most comprehensive AST assay based on microfluidics design
Automated system with competitive unit costs and 60-panel throughput
Intended use: isolates and positive blood cultures
Single panel for G+ G-
Determination of Real MIC for each antibiotic
Just two simple steps to prepare the sample
Integrated with existing systems
Easy-to-use
Market launch H2/2025
BACTEROMIC – Faster Access to Precise and Effective Antibiotic Therapies
BACTEROMIC consists of an analyzer, a filler, and panels for assessing antibiotic susceptibility. It is an automated system, significantly simplifying and shortening laboratory procedures used in the evaluation of microorganism susceptibility.
Microfluidic solutions are the heart of BACTEROMIC system.
BACTEROMIC is a combination of the gold standard dilution method with the use of advanced microfluidics and built-in artificial intelligence, offering the ability to test all relevant antibiotics in a single test.
BACTEROMIC offers a comprehensive antibiogram.
Highest information capacity
640 incubation chambers
High
efficiency
– up to 60 panels in a single test
Fully compliant
with the
EUCAST/ CLSI guidelines
Assessment of the real (MIC)
across a wide range of concentrations – 6-14 per each antibiotic
Diagnostic panel
One panel – a complete set of reliable information
The BACTEROMIC system allows for a one-time identification of the effectiveness of a range of up to 31 antibiotics used in the treatment of, among others, respiratory, blood, urinary tract, and skin infections. It provides a quick and accurate assessment of the antibiotic susceptibility of both G+ G- bacteria in a single diagnostic panel.
Single panel for G+ and G- bacteria

Each incubation chamber is connected to a chamber that serves as an air reservoir to ensure the growth of aerobic bacteria.

The incubation chambers are separated by a non-polar liquid, creating a barrier that prevents the diffusion of antibiotics.
BACTEROMIC Panel UNI 2.0
up to 31 antibiotics + ESBL resistance mechanism
Pre-IVDR
No of panels
One panel for G+ and G- bacteria (21 Gram +, 22 Gram -)
Time of AST
16 h
No of antibiotics
up to 31 antibiotics + ESBL resistance mechanism
BACTEROMIC Panel UNI - List of resistance mechanism tests
Bacteromic Panel UNI -
List of antibiotics (G+ and G-) by group
Aminoglycosides
Gram-negative (G-)
Gram-positive (G+)
Amikacin
Gentamicin
Tobramycin
Diaminopyrimidines
Gram-negative (G-)
Gram-positive (G+)
Trimethoprim
Trimethoprim/sulfamethoxazole
Carbapenems
Gram-negative (G-)
Gram-positive (G+)
Imipenem
Meropenem
Lincosamides
Gram-negative (G-)
Gram-positive (G+)
Clindamycin
Fluoroquinolones
Gram-negative (G-)
Gram-positive (G+)
Ciprofloxacin
Levofloxacin
Moxifloxacin
Ofloxacin
Nitrofurans
Gram-negative (G-)
Gram-positive (G+)
Nitrofurantion
Glycopeptides
Gram-negative (G-)
Gram-positive (G+)
Vancomycin
Penicillinis
Gram-negative (G-)
Gram-positive (G+)
Amoxicillin
Amoxicillin-clavulanic acid
Ampicillin
Oxacillin
Benzylpanicillin
Cephalosporins
Gram-negative (G-)
Gram-positive (G+)
Cefepime
Cefotaxime
Ceftazidime
Ceftazidime-avibactam
Ceftriaxone
Cefuroxime
Cephazolin
Macrolides
Gram-negative (G-)
Gram-positive (G+)
Azithromycin
Clarithromycin
Erythromycin
Oxazolidinones
Gram-negative (G-)
Gram-positive (G+)
Linezolid
NEW PANELS ARE COMING SOON
BACTEROMIC Panel Rapid UNI
In development
Sample type
Bacteria Isolates
Time of AST
6 – 8 h (same shift results)
BACTEROMIC Panel BSI
In development
Sample type
Positive Blood Culture
Time of AST
6 – 8 h (same shift results)
BACTEROMIC Panel UNI MAX
In development
Sample type
Bacteria Isolates
Time of AST
16 h
Procedure
Step 1
Transfer bacterial isolate onto the panel
Step 2
Automated partitioning of the sample into microchambers - up to 10 panels in parallel
Step 3
Automated analysis of up to 60 panels in parallel, with random access, real-time reporting, and LIS connectivity
Procedure of use
Studies conducted in specialist diagnostic centres have confirmed the functionality of the BACTEROMIC system in effective identification of the drug susceptibility of bacteria causing a number of infections.
As emphasized by doctors and experts from the World Health Organization (WHO), antibiotic resistance is one of the most serious issues in modern medicine.

An isolated bacterial strain

A monocultural bacterial suspension

Transferring the suspension onto the catridge

Closing
the cap

Place the panels in the rack

Transfer filled panels to Analyzer

Fully automated analysis for up to 60 samples
Procedure of use
Studies conducted in specialist diagnostic centres have confirmed the functionality of the BACTEROMIC system in effective identification of the drug susceptibility of bacteria causing a number of infections.
as emphasized by doctors and experts from the World Health Organization (WHO), antibiotic resistance is one of the most serious issues in modern medicine.
An isolated bacterial strain

A monocultural bacterial suspension

Transferring the suspension onto the catridge

Closing
the cap

Place the panels in the rack

Transfer filled panels to Analyzer

Fully automated analysis for up to 60 samples
Technology
Target Audience
BACTEROMIC is an excellent solution for:
Hospitals
Central
Labs
Microbiology
Labs
Development
2025
- Publication of Analytical Performance Evaluation of BACTEROMIC system results
2024
- Scope Fluidics launches Analytical Performance Evaluation of BACTEROMIC system at second center
- BACTEROMIC system 2.0 under IVDR certification process
2023
- BACTEROMIC secures U.S. Patent for Ultra-Fast Antimicrobial Susceptibility Testing Method and System
- Scope Fluidics launches Analytical Performance Evaluation for BACTEROMIC system
2022
- Development of BACTEROMIC system 2.0
- BACTEROMIC Panel UNI composition update
- Implementation of the Analytical Performance Evaluation
2021
- Obtaining the ISO 13485:2016 certification
- Clinical validation of the BACTEROMIC system
Early Access Program
performance data
Precision
In the BACTEROMIC precisely determined the minimum inhibitory concentration (MIC) in tested range of concentrations for 96% of antibiotic–bacteria pairs, compared to 38% in competing solutions.
Reliability
EA and CA agreement rates against very common automated AST being 93% and 94%, respectively, for both GN and GP bacteria underscore the high quality and consistency of our panels.
Next Steps
With this significant milestone achieved, we’re moving forward with further verifications in Europe and outside, bringing us closer to delivering an even more advanced diagnostic tool worldwide.

The project has received funding from the European Union's HORIZON 2022 research and innovation programme under contract no. 881101.

Obtaining international patent protection for the inventions ‘Microfluidic chip and Incubation segment’